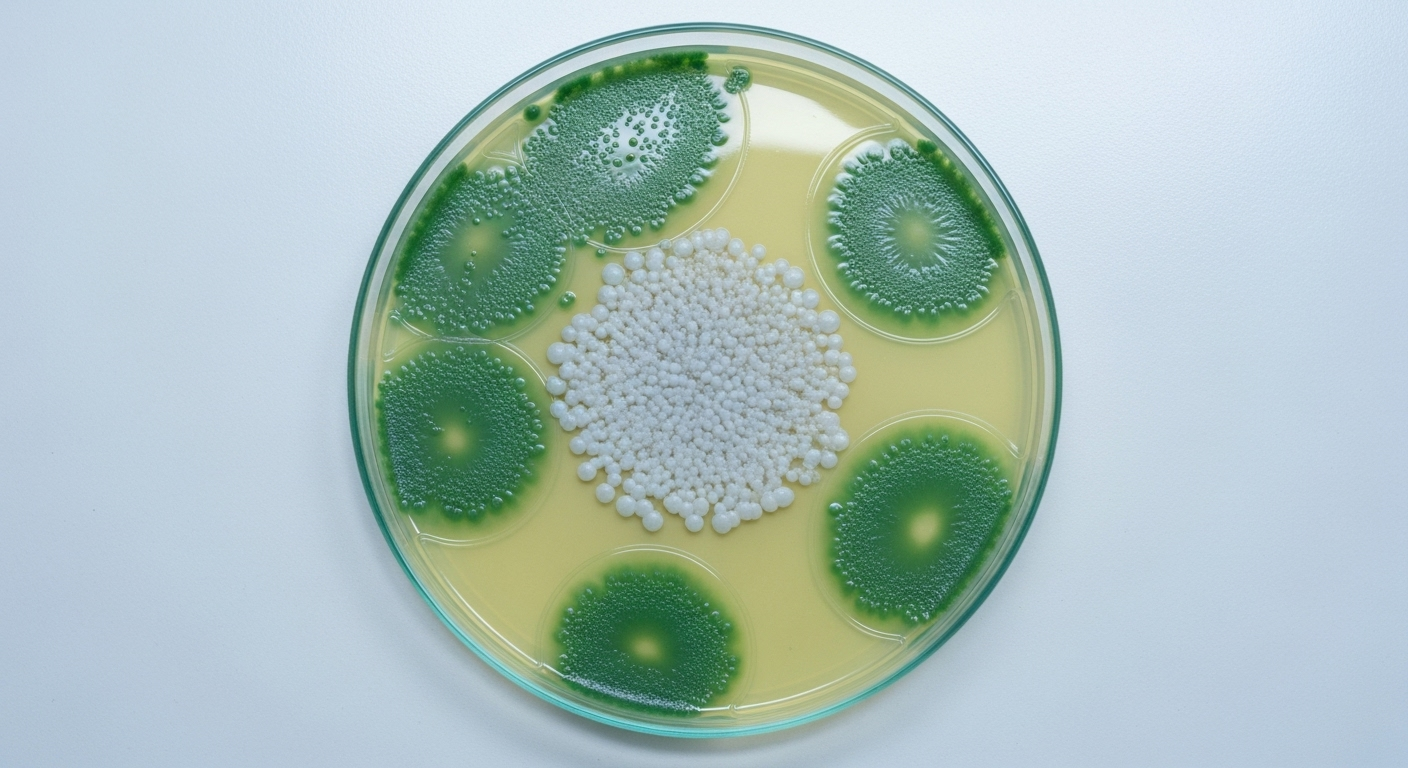
Une pharmacie à l'échelle du microbe

Découverte surprenante : le pollen des fleurs pourrait être l’arme naturelle qui sauvera les abeilles et nos récoltes
Auteur: Adam David
On le sait, les abeilles vont mal. Menacées par une trentaine d’agents pathogènes, des virus aux parasites, leur déclin fragilise nos écosystèmes et notre sécurité alimentaire. Face à des traitements chimiques qui montrent leurs limites, une équipe de chercheurs américains a regardé là où personne ne s’y attendait : au cœur même du pollen que les abeilles rapportent à la ruche.
Dans le pollen, un monde microbien insoupçonné

Jusqu’ici, le pollen était surtout vu comme une simple source de protéines pour la colonie. Mais ce que révèle une étude publiée dans Frontiers in Microbiology, c’est que cette poudre dorée est loin d’être stérile. Elle est en réalité un véhicule pour une myriade de micro-organismes, un véritable écosystème en miniature.
Les chercheurs du Washington College et de l’Université du Wisconsin-Madison y ont isolé 34 souches de bactéries, dont une grande majorité (72 %) appartient au genre Streptomyces. Un nom bien connu des biologistes, car ces bactéries sont de véritables usines à produire des composés antimicrobiens. Le fait de les retrouver à la fois sur les fleurs, sur les butineuses et dans le pollen stocké suggère un transfert constant, une sorte de service de livraison naturel.
Une pharmacie à l'échelle du microbe
Pour comprendre le potentiel de cette découverte, l’équipe a mis ces bactéries à l’épreuve. Elles ont été confrontées à six pathogènes redoutables : trois qui s’attaquent aux abeilles, et trois qui dévastent les cultures. Les résultats sont saisissants. Pratiquement toutes les souches de Streptomyces ont réussi à bloquer la croissance d’Aspergillus niger, le champignon responsable de la maladie du « couvain plâtré », qui momifie les larves.
Une efficacité notable a aussi été observée contre Paenibacillus larvae, la bactérie qui cause la loque américaine, une infection mortelle et très contagieuse pour les couvains. Côté plantes, ces mêmes microbes ont inhibé des agents qui provoquent des maladies sur des cultures aussi vitales que le pommier, la tomate ou la pomme de terre.
L'origine de ces alliées : les plantes elles-mêmes

Mais d’où viennent ces précieux microbes ? L’analyse génomique a levé le voile. Il ne s’agit pas de passagers clandestins, mais de symbiotes végétaux, ce que les scientifiques appellent des endophytes. Ces bactéries vivent à l’intérieur même des tissus de la plante. Elles colonisent les fleurs, puis se retrouvent embarquées dans les grains de pollen.
Les abeilles, en butinant, ne font donc pas que récolter de la nourriture. Elles moissonnent sans le savoir une véritable armée de protecteurs qu’elles rapportent à la ruche. C’est un exemple fascinant d’une alliance à trois bandes : la plante, le microbe et l’insecte. Un équilibre subtil où la diversité florale d’un paysage devient la meilleure assurance-vie pour les colonies.
Vers une alternative aux antibiotiques de synthèse

Aujourd’hui, pour lutter contre les maladies des ruches, les apiculteurs ont souvent recours à des antibiotiques comme l’oxytétracycline. Le problème, c’est que leur usage massif a des conséquences : il perturbe le système digestif des abeilles, contamine le miel et, surtout, favorise l’émergence de résistances. Certains pathogènes n’y sont déjà plus sensibles.
L’idée serait donc d’imiter la nature. Plutôt que de traiter avec des produits chimiques, on pourrait enrichir l’environnement des ruches avec ces souches bénéfiques de Streptomyces. Une sorte de probiotique pour la colonie. Cette approche biologique, plus douce et ciblée, renforcerait les défenses naturelles de la ruche sans perturber son équilibre fragile.
de la ruche au champ, une même logique

Cette recherche dépasse largement la seule santé des abeilles. Elle nous rappelle à quel point la résilience d’un écosystème repose sur des interactions invisibles. Les mêmes bactéries qui protègent la ruche pourraient demain être utilisées pour protéger les cultures, réduisant notre dépendance aux pesticides de synthèse.
Finalement, cette découverte réhabilite une idée simple : pour sauver les pollinisateurs et garantir nos récoltes, la meilleure stratégie est peut-être de préserver des environnements riches et diversifiés. C’est dans cette complexité florale que se cachent les clés d’une agriculture et d’une apiculture vraiment durables.
Selon la source : science-et-vie.com










